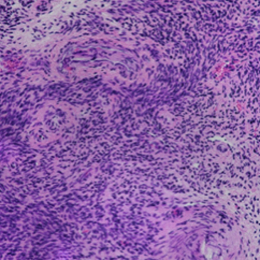

Price | 1784€+ Login to see price |
Organism | Human |
Product Type | Organoid |
Tissue | Endometrial cancer |
Disease | Endometrial cancer |
Oncology
The oncology drug efficacy evaluation platform is based on patient-derived organoids(PDOs).
This platform allows for the assessment of the efficacy of oncology agents and immunotherapeutics by utilizing a co-culture system with immune cells from the tumor microenvironment.
Immuno-Oncology
This provides a solution for assessing the effectiveness of immunotherapeutic agents targeting cytotoxic T cells in co-culture with cancer organoids.
Tumormicroenvironment
CAFs promote cancer invasion and metastasis, potentially inducing resistance to anticancer drugs. Considering these functions of CAFs is crucial for accurately assessing the efficacy of anticancer drugs and developing strategies to address these challenges.
Cancer Vaccine
Lead the future of treatment with our innovative cancer vaccine and mRNA therapy platform.
Discover advanced solutions that provide better health and hope through our cutting-edge technology and scientific approach

“...However, predicting drug responsiveness has been challenging due to variability between patients. Lambda Biologics’ patient-derived organoids address this issue by reflecting the unique characteristics of individual patients. These organoids allow...

“...However, predicting drug responsiveness has been challenging due to variability between patients. Lambda Biologics’ patient-derived organoids address this issue by reflecting the unique characteristics of individual patients. These organoids allow...
Utilize our precision-engineered endometrial cancer organoids for effective therapy development and detailed tumor analysis. These organoids replicate patient tumor characteristics, offering a robust model for exploring targeted treatments and hormone dynamics. Transform endometrial cancer research and accelerate discovery with our advanced organoid platform.


We performed immunofluorescence staining on our endometrial cancer organoids to confirm their similarity to patient tissue. The results demonstrated that both pan-cytokeratin (Pan-CK), an epithelial cell marker, and Vimentin (VIM), an endometrial cancer tumor marker, were expressed in a pattern similar to the patient tissue. Additionally, the expression of anti-estrogen receptor (ER-α) and anti-progesterone receptor (PR) in the organoids mirrored that in the patient tissue. These organoids, which faithfully replicate the cellular and molecular characteristics of the primary tumor, offer a powerful platform for developing and testing targeted treatments, studying tumor behavior, and exploring hormone receptor dynamics in endometrial cancer.
H&E | Pan-CK | VIM | ER-a | PR | |
|---|---|---|---|---|---|
Cancer tissue | |  |  | ||
Cancer organoid |  |  |  | ||